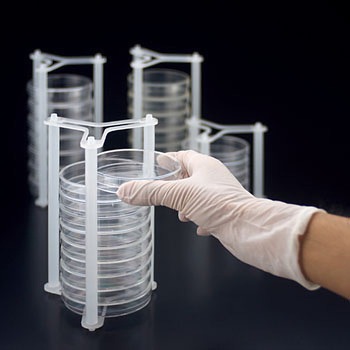

サンプラ(R) ペトリマルチラック
側面から出し入れできる外径Φ90mm専用のシャーレラックです。
側面の出し入れが可能です。
ラックごとひっくり返せるので菌培養時に便利です。
積み重ねたシャーレをラック毎安定移動できます。
省スペース設計の為インキュベーター内でもスペースロスが生じない形状です。
オートクレーブも可能です。
用途菌培養シャーレのラックとして寸法(Φmm)90内容量1個
バイオ・食品(菌)関連用品 の新着商品
カテゴリ



商品レビュー
よくあるご質問(FAQ)
- 質問:
- 役立つ情報などございますか
- 回答:
- 下記のタイトルの内容でお役に立てるなら、URLのリンク先ご確認ください。
シャーレの特長と使い方
豆知識URL:
https://www.monotaro.com/note/cocomite/839/
2022-09-22
- 質問:
- 製品の安全データシート(SDS)や有害物質使用制限に関するデータ(RoHS)等の書面が必要ですがどうすれば良いですか。
- 回答:
- お手数ですが下記URLのお問合せフォームよりご依頼ください。
お問合せ種類 *必須の中から必要な書類をお選びご依頼ください。
https://help.monotaro.com/app/ask
書類名)
1:SDS(MSDS)
2:RoHS(2)
3:非該当証明書
4:ChemSHERPA
5:その他(ミルシート・出荷証明書)
2022-04-07